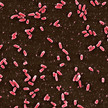
Pseudomonas aeriginosa Camilo Barbosa Dr Phillipp Dirksen Bakterien in der Sackgasse

Thema: Studien
Artikel zum Thema
Kosmetika Deos: Krebsrisiko wegen Aluminium
Die Verwendung von aluminiumhaltigen Deodorants wird kontrovers diskutiert, denn das Metall wird häufig mit dem Auftreten von Alzheimer und Brustkrebs in... Mehr»
James P. Allison Der Erfinder der Checkpoint-Therapie
Als Kind verlor James P. Allison seine Mutter an den Krebs. Später revolutionierte er dessen Behandlung, indem er den vollständig humanisierten monoklonalen... Mehr»
Arzneimittelrisiken Bild: 3000 Aspirin-Tote jährlich
Einer Studie der Oxford University zufolge sterben in Großbritannien jährlich etwa 3000 Patienten an Blutungen, die von Präparaten mit Acetylsalicylsäure (ASS)... Mehr»
Molekularbiologie Gifttransporter: 3D-Struktur entschlüsselt
Körpereigene Transportproteine schleusen xenobiotische Substanzen aus dem Organismus und dienen damit als Schutzmechanismus. Bei einer Arzneimitteltherapie... Mehr»
Fast jeder dritte Mensch ist übergewichtig. Die Rate der Fettleibigen steigt rasch, besonders unter Kindern. Forscher sprechen von einem der schwierigsten... Mehr»
Herz-Kreislauf-Erkrankungen Atherosklerose: Darmbakterien im Visier
Neben Faktoren wie Übergewicht, Hypertonie und Diabetes werden auch Darmbakterien in Verbindung mit kardiovaskulären Erkrankungen gebracht. Grund dafür ist die... Mehr»
Haarausfall Keine Tregs, keine Haare
Sie kann mit Würde getragen werden, ein Modetrend oder ungewollt das Resultat von Haarausfall sein – die Glatze. Die Apotheke bietet zahlreiche Möglichkeiten,... Mehr»
COPD-Medikamente Braltus/Spiriva: Warum 13 dasselbe wie 18 ist
Als vor einem Jahr mit Braltus ein Generikum zu Spiriva (Tiotropiumbromid) auf den Markt kam, waren viele Apothekenmitarbeiter verunsichert. Immerhin standen... Mehr»
Antibiotikaresistenzen Bakterien in der Sackgasse
Antibiotikaresistenzen sind eine zunehmende Gefahr für die öffentliche Gesundheit, denn immer mehr Erreger sprechen nicht mehr auf die gewohnte Therapie an.... Mehr»
Krankenhauskeime Mit mRNA gegen MRSA
In Krankenhäusern gilt der multiresistente Staphylococcus aureus (MRSA) als besondere Gefahr, da er für schwere Infektionen verantwortlich ist. Der Erreger ist... Mehr»
Medien zum Thema
- 1